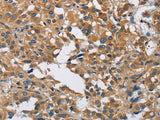
DNMT3A Polyclonal Antibody Store at -20°C - MSE Supplies LLC

DNMT3A Polyclonal Antibody Store at -20°C
SKU: E-AB-14623-200
DNMT3A Polyclonal Antibody Store at -20°C
| SKU # | E-AB-14623 |
| Reactivity | Human, Mouse, Rat |
| Host | Rabbit |
| Applications | IHC |
Product Details
| Isotype | IgG |
| Host | Rabbit |
| Reactivity | Human, Mouse, Rat |
| Applications | IHC |
| Clonality | Polyclonal |
| Immunogen | Recombinant protein of human DNMT3A |
| Abbre | DNMT3A |
| Synonyms | DNA (cytosine 5) methyltransferase 3 alpha, DNA (cytosine 5) methyltransferase 3A, DNA (cytosine-5)-methyltransferase 3A, DNA MTase HsaIII, DNA cytosine methyltransferase 3A2, DNA methyltransferase 3 alpha, DNA methyltransferase 3a, DNA methyltransferase HsaIIIA |
| Swissprot | |
| Cellular Localization | Nucleus. Cytoplasm. Accumulates in the major satellite repeats at pericentric heterochromatin. |
| Concentration | 0.4 mg/mL |
| Buffer | Phosphate buffered solution, pH 7.4, containing 0.05% stabilizer and 50% glycerol. |
| Purification Method | Affinity purification |
| Research Areas | Cancer, Epigenetics and Nuclear Signaling |
| Conjugation | Unconjugated |
| Storage | Store at -20°C Valid for 12 months. Avoid freeze / thaw cycles. |
| Shipping | The product is shipped with ice pack,upon receipt,store it immediately at the temperature recommended. |
Related Reagents
| Applications | Recommended Dilution |
| IHC | 1:50-1:200 |
Background
CpG methylation is an epigenetic modification that is important for embryonic development, imprinting, and X-chromosome inactivation. Studies in mice have demonstrated that DNA methylation is required for mammalian development. This gene encodes a DNA methyltransferase that is thought to function in de novo methylation, rather than maintenance methylation. The protein localizes to the cytoplasm and nucleus and its expression is developmentally regulated. Alternative splicing results in multiple transcript variants encoding different isoforms.